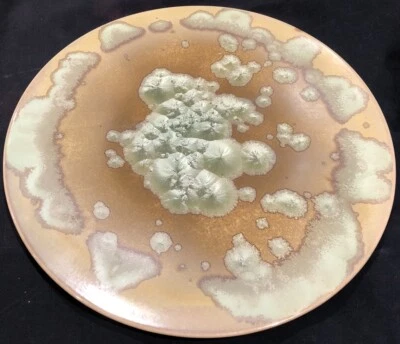
PIERREFONDS GRÈS BEAU PLAT SABLE EMAUX CRISTALLISÉS VERT D’EAU BEL EFFET IRISÉ - Photo 1/4

Pierrefonds dans grès du xxe siècle
Explorer par catégorie
40 résultats
Trier : Pertinence
- 59,00 EUR7,00 EUR de frais de livraisonLivraison en point de retrait disponible
- Particulier90,00 EURou Offre directe8,00 EUR de frais de livraison
- 140,00 EURLivraison internationale gratuite
- 220,00 EURou Offre directe7,50 EUR de frais de livraisonLivraison en point de retrait disponibleSuivi par 11 personnes
- 39,00 EUR8,00 EUR de frais de livraisonLivraison en point de retrait disponible
- 29,99 EUR8,00 EUR de frais de livraisonLivraison en point de retrait disponible
- 395,00 EURou Offre directe8,00 EUR de frais de livraisonLivraison en point de retrait disponible
- 30,00 EURou Offre directe8,00 EUR de frais de livraisonLivraison en point de retrait disponible0 enchères5 j 15 h
- 35,00 EURou Offre directe11,00 EUR de frais de livraisonLivraison en point de retrait disponible
- 12,00 EUR3,80 EUR de frais de livraisonLivraison en point de retrait disponible
- 80,00 EURou Offre directe5,00 EUR de frais de livraisonLivraison en point de retrait disponibleSuivi par 14 personnes
- 80,00 EURou Offre directe28,50 EUR de frais de livraison
- Professionnel65,00 EUR9,00 EUR de frais de livraison
- 100,00 EURou Offre directe13,00 EUR de frais de livraison
- 65,00 EUR7,49 EUR de frais de livraisonLivraison en point de retrait disponible
- 30,00 EURLivraison internationale gratuite
- 300,00 EUR30,00 EUR de frais de livraison
- 190,00 EURou Offre directe18,00 EUR de frais de livraison
- 30,00 EURou Offre directe8,00 EUR de frais de livraisonLivraison en point de retrait disponible
- 99,90 EURou Offre directe14,00 EUR de frais de livraison
- 225,00 EURou Offre directe9,00 EUR de frais de livraisonLivraison en point de retrait disponible
- Professionnel30,00 EUR14,00 EUR de frais de livraisonLivraison en point de retrait disponibleSuivi par 15 personnes
- 180,00 EURou Offre directe9,00 EUR de frais de livraison
- Particulier59,00 EUR6,00 EUR de frais de livraisonLivraison en point de retrait disponible
- 240,00 EUR11,50 EUR de frais de livraisonLivraison en point de retrait disponible
- 49,99 EURou Offre directe7,50 EUR de frais de livraison
- 25,00 EUR9,70 EUR de frais de livraisonSuivi par 13 personnes
- 200,00 EUR7,00 EUR de frais de livraisonLivraison en point de retrait disponible
- 180,00 EURLivraison internationale gratuite
- 29,99 EURou Offre directe7,00 EUR de frais de livraisonLivraison en point de retrait disponible
- 140,00 EUR6,60 EUR de frais de livraisonLivraison en point de retrait disponible
- 180,00 EURou Offre directe35,00 EUR de frais de livraisonLivraison en point de retrait disponible
- 90,00 EURou Offre directe16,00 EUR de frais de livraison
- 18,00 EUR5,00 EUR de frais de livraisonLivraison en point de retrait disponible
- 60,00 EURou Offre directe12,40 EUR de frais de livraisonLivraison en point de retrait disponible
- 125,00 EURou Offre directe18,00 EUR de frais de livraison
- Professionnel50,00 EURou Offre directe9,00 EUR de frais de livraison
- Particulier165,00 EURou Offre directe16,00 EUR de frais de livraisonLivraison en point de retrait disponible
- Professionnel29,00 EUR9,00 EUR de frais de livraison
- 180,00 EURou Offre directeLivraison internationale gratuite